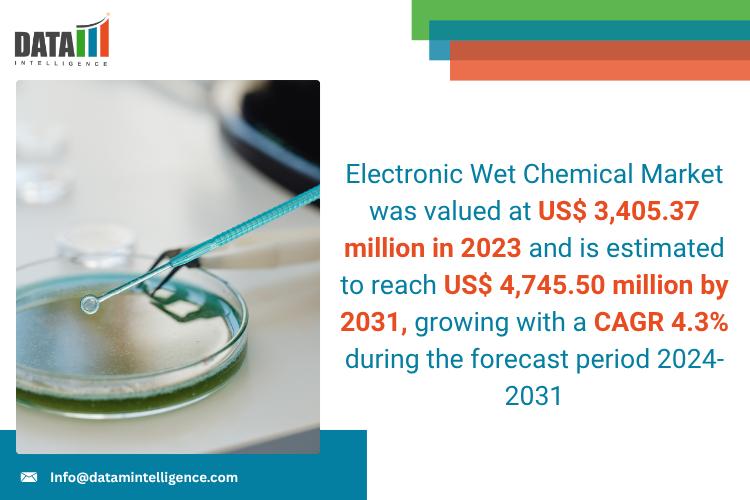
Electronic Wet Chemical Market - DataM Intelligence

Press release
United States Electronic Wet Chemical Market 2025: Industry Developments, Future Growth, Share & Industry Insights | Linde PLC, FUJIFILM Holdings Corporation, Eastman Chemical Company, Kanto Chemical
Electronic Wet Chemical Market was valued at US$ 3,405.37 million in 2023 and is estimated to reach US$ 4,745.50 million by 2031, growing with a CAGR 4.3%during the forecast periodDataM Intelligence has published a new research report on "Electronic Wet Chemical Market Size 2025". The report explores comprehensive and insightful Information about various key factors like Regional Growth, Segmentation, CAGR, Business Revenue Status of Top Key Players and Drivers. The purpose of this report is to provide a telescopic view of the current market size by value and volume, opportunities, and development status.
Get a Free Sample PDF Of This Report (Get Higher Priority for Corporate Email ID):- https://datamintelligence.com/download-sample/electronic-wet-chemical-market?sg
Key Players: BASF SE, Avantor Inc., Entegris, Inc, Solvay, Technic Inc., Avient Corporation, Linde PLC, FUJIFILM Holdings Corporation, Eastman Chemical Company, Kanto Chemical Co. Inc.
USA - Industry Latest News 2025:
✅ 04 May 2025 - Fujifilm (via its FUJIFILM Electronic Materials business) won Intel's 2025 EPIC Supplier Award, recognising its supply-chain performance and positioning Fujifilm as a key supplier of electronic chemicals to U.S. fabs and OEMs.
✅ (ongoing 2025 - corporate integration) - Fujifilm completed acquisition of Entegris' Electronic Chemicals business (transaction announced 2023, closed Oct 2023); through 2024-25 Fujifilm continued to integrate those assets and to market the acquired CMP/wet-process and high-purity chemical lines in the U.S.
✅ 15 Mar 2025 - U.S. expansion by Korean supplier (example: Dongjin Semichem) - Dongjin announced/advanced its U.S. expansion plans (Killeen, Texas facility expansion activity reported in early 2025), adding local production capacity for semiconductor/display chemicals in the U.S. market. This reflects a trend of non-U.S. wet-chemical suppliers building U.S. footprint to service fabs.
Japan - Industry Latest News 2025:
✅ 15 Apr 2025 - FUJIFILM Electronic Materials earned Intel's EPIC Supplier Award for 2025 and continued to highlight new product & capacity rollouts (CMP slurries, high-purity etchants/cleaners) tied to the former Entegris electronic-chemicals assets.
✅ Jan 2024 → Spring 2025 (facility start) - FUJIFILM's Kumamoto site investment (CMP slurries / process chemicals) was scheduled to enter full operation by spring 2025 - a Japan plant coming online that affects wet-chemical supply in 2025.
✅ 2025 (company R&D & plant moves) - Major Japanese electronic-materials groups (JSR, TOK/TOKYO OHKA KOGYO, Shin-Etsu, Sumitomo) continued facility/R&D expansions in 2025 focused on high-purity cleaning chemistries, CMP slurries and resist ancillaries - multiple company press updates and IR notices in 2025 show capacity/R&D investments (examples: TOK and JSR news pages / IR).
Korea - Industry Latest News 2025:
✅ 15 Feb 2025 - Dongjin Semichem announced/advanced an expansion of operations in Killeen, Texas (reported Feb 15, 2025), establishing/expanding local production for display and semiconductor materials (including wet chemicals). This is a concrete 2025 cross-border capacity expansion relevant to wet chemicals.
✅ Apr 15, 2025 (corporate action) - Soulbrain (Korean electronic-materials supplier) undertook corporate actions in 2025 (share buyback disclosure / other corporate filings during 2025) - signals balance-sheet activity and continued role as a supplier of high-purity wet chemicals to regional fabs. (company disclosures / markets coverage).
✅ through 2025 - Korean suppliers (Dongjin, Soulbrain and others) continued to expand overseas distribution/production and to win supply contracts for advanced nodes - part of a broader regional push to localize wet-chemical supply chains for fabs in Korea and the U.S.
Europe - Industry Latest News 2025:
✅ 07 Aug 2025 (Q2 results / corporate update covering Q2 2025) - Merck KGaA (Semiconductor Materials / Electronics division) reported sustained demand for semiconductor materials and continued investments and partnerships in 2025; Merck's 2025 press materials highlight ongoing investments in electronics materials capacity and collaborations across packaging/wet-process areas. (Merck Q2 2025 release / media pack.)
✅ 04 Aug 2025 - Merck KGaA + Electroninks partnership announced (August 4, 2025): a collaboration to co-develop next-generation Back-Side Metallization (BSM) / thermal-management materials for advanced packaging - while Electroninks is an additive-ink supplier, the tie-up points to material innovations adjacent to wet chemical and process chemistries used in packaging and panel processes. This is a notable 2025 product/technology partnership out of Europe / U.S. announcements.
Growth Forecast Projected:
The Global Electronic Wet Chemical Market is anticipated to rise at a considerable rate during the forecast period, between 2025 and 2032. In 2024, the market is growing at a steady rate, and with the rising adoption of strategies by key players, the market is expected to rise over the projected horizon.
Research Process:
Both primary and secondary data sources have been used in the global Electronic Wet Chemical Market research report. During the research process, a wide range of industry-affecting factors are examined, including governmental regulations, market conditions, competitive levels, historical data, market situation, technological advancements, upcoming developments, in related businesses, as well as market volatility, prospects, potential barriers, and challenges.
Purchase this report before year-end and unlock an exclusive 30% discount: - https://www.datamintelligence.com/buy-now-page?report=electronic-wet-chemical-market?sg
(Purchase 2 or more Repots and get 50% Discount)
Key Segments:
By Type (Acetic Acid (CH3OOH), Isopropyl Alcohol (IPA) (C3H8O), Hydrogen Peroxide (H2O2), Hydrochloric Acid (HCL), Ammonium Hydroxide (NH4OH), Hydrofluoric Acid (HF), Nitric Acid (HNO3), Phosphoric Acid (H3PO4), Sulfuric Acid (H2SO4), Others)
By Application (Semiconductor Doping, Etching, Cleaning, Packaging, Others)
By End-User (Consumer Goods, Automotive, Aerospace & Defense, Medical, Others)
Regional Analysis for Market:
⇥ North America (U.S., Canada, Mexico)
⇥ Europe (U.K., Italy, Germany, Russia, France, Spain, The Netherlands and Rest of Europe)
⇥ Asia-Pacific (India, Japan, China, South Korea, Australia, Indonesia Rest of Asia Pacific)
⇥ South America (Colombia, Brazil, Argentina, Rest of South America)
⇥ Middle East & Africa (Saudi Arabia, U.A.E., South Africa, Rest of Middle East & Africa)
Benefits of the Report:
Chapter 1: Sets the stage by outlining the report's coverage, summarizing key market segments by region, product type, and application. Presents a snapshot of market sizes, growth potential across segments, and anticipated industry evolution both short and long term.
Chapter 2: Highlights pivotal market insights and uncovers the most significant emerging trends driving change within the industry.
Chapter 3: Offers an in-depth look at the competitive landscape among Electronic Wet Chemical producers, including revenue shares, strategic moves, and recent mergers and acquisitions.
Chapter 4: Presents comprehensive profiles of the market's key players, delving into details such as revenue, profit margins, product portfolios, and company milestones.
Chapters 5 & 6: Analyze Electronic Wet Chemical revenue at both regional and country levels, providing quantitative breakdowns of market sizes, growth opportunities, and development prospects worldwide.
Chapter 7: Focuses on different market segments by type, examining their individual sizes and potential, guiding readers toward high-impact, untapped market areas.
Chapter 8: Explores segmentation by application, evaluating industry growth potential in various downstream markets and pinpointing promising sectors for expansion.
Chapter 9: Provides a thorough review of the industry's supply chain mapping out both upstream and downstream activities.
Chapter 10: Concludes with a summary of the report's key findings and highlights the most critical takeaways for industry stakeholders.
Get Customization in the report as per your requirements: https://datamintelligence.com/customize/electronic-wet-chemical-market?sg
FAQ's
Q1: What is the current size of the Electronic Wet Chemical Market?
A: The Electronic Wet Chemical Market stood at US$ 3,405.37 million in 2023 and is set to experience remarkable growth, reaching US$ 4,745.50 million by 2031
Q2: How fast is the Electronic Wet Chemical Market growing?
A: The Market is on an impressive growth trajectory, expected to expand at a CAGR of 4.3% from 2024-2031
Q3: Which regions are dominating the Electronic Wet Chemical Market and which are fastest-growing?
A: Asia-Pacific is also a global leader in producing several commercial and industrial items.
Have any Query We Will Provide in Detailed @ https://www.datamintelligence.com/enquiry/electronic-wet-chemical-market?sg
Power your decisions with real-time competitor tracking, strategic forecasts, and global investment insights all in one place.
Have a look at our Subscription Dashboard: https://www.youtube.com/watch?v=x5oEiqEqTWg
Get 2-Day Free Trial + 50% OFF DataM Subscription@ https://www.datamintelligence.com/reports-subscription?sg
Contact Us -
Company Name: DataM Intelligence
Contact Person: Sai Kiran
Email: Sai.k@datamintelligence.com
Phone: +1 877 441 4866
Website: https://www.datamintelligence.com
About Us -
DataM Intelligence is a Market Research and Consulting firm that provides end-to-end business solutions to organizations from Research to Consulting. We, at DataM Intelligence, leverage our top trademark trends, insights and developments to emancipate swift and astute solutions to clients like you. We encompass a multitude of syndicate reports and customized reports with a robust methodology.
Our research database features countless statistics and in-depth analyses across a wide range of 6300+ reports in 40+ domains creating business solutions for more than 200+ companies across 50+ countries; catering to the key business research needs that influence the growth trajectory of our vast clientele.
This release was published on openPR.
Permanent link to this press release:
Copy
Please set a link in the press area of your homepage to this press release on openPR. openPR disclaims liability for any content contained in this release.
You can edit or delete your press release United States Electronic Wet Chemical Market 2025: Industry Developments, Future Growth, Share & Industry Insights | Linde PLC, FUJIFILM Holdings Corporation, Eastman Chemical Company, Kanto Chemical here
News-ID: 4251159 • Views: …
More Releases from DataM Intelligence 4 Market Research LLP
Application-Specific Integrated Circuit (ASIC) Market Set for Steady Growth to U …
The Global Application-Specific Integrated Circuit (ASIC) Market reached US$ 15.7 billion in 2022 and is expected to reach US$ 34.5 billion by 2030, growing with a CAGR of 8.3% during the forecast period 2023-2030. This sustained growth is driven by the explosive demand for high-performance, energy-efficient silicon for artificial intelligence (AI) inferencing, cryptocurrency mining, and advanced wireless communication (5G/6G), coupled with the increasing need for customized acceleration solutions across automotive,…
Asthma and COPD Drug Market to Witness Steady Growth, Fueled by Innovation and H …
The Global Asthma and COPD Drug Market is expected to grow at a CAGR of 3.9% during the forecast period (2024-2031). This steady growth is propelled by the persistently high and rising global prevalence of chronic respiratory diseases, continuous innovation in biologic therapies and smart inhaler technologies, and the expanding aging population more susceptible to COPD, driving long-term treatment demand.
Get a Free Sample PDF Of This Report (Get Higher Priority…
Ambulatory Blood Pressure Monitors Market Set for Strong Growth to USD 3.42 Bill …
The Global Ambulatory Blood Pressure Monitors (ABPM) Market reached US$ 1.33 billion in 2024 and is expected to reach US$ 3.42 billion by 2033, growing at a CAGR of 11.2% during the forecast period 2025-2033. This robust growth is propelled by the rising global prevalence of hypertension, the increasing clinical preference for 24-hour ABPM over clinic readings for accurate diagnosis and treatment monitoring, and technological advancements that enhance device connectivity…
Advanced Wound Care Market Poised for Steady Growth, Driven by Rising Chronic Wo …
The Global Advanced Wound Care Market was valued at USD 10,318.90 million in 2021 and is forecast to grow at a CAGR of 4.90% during the forecast period (2024-2031). This steady growth is fueled by the increasing global prevalence of chronic wounds, such as diabetic foot ulcers and venous leg ulcers, the aging global population, and continuous advancements in wound therapy technologies that improve healing times and patient outcomes.
Get a…
More Releases for Electronic
Revolutionizing Electronic Warfare: The Power of Cognitive Electronic Warfare Sy …
According to the report published by Allied Market Research, " Cognitive Electronic Warfare System Market by Capability (Electronic Attack, Electronic Protection, Electronic Support, Electronic Intelligence) and by Platform (Naval, Airborne, Land, Space): Global Opportunity Analysis and Industry Forecast, 2023-2032 "Cognitive electronic warfare systems are based on learning action frameworks that use machine learning algorithms and artificial intelligence (AI) to mimic human perception of learning, memory, and judgement. Machine learning, being…
Electronic Cigarettes
Electronic Cigarettes are also known as Vaping, which consist of different type of devices that allow the users to inhale an aerosol that might be nicotine, flavoring and other species. Electronic Cigarettes market is expected to mark significant growth over forecasted period owing to increasing technological advancements, change in lifestyle and consists of various flavours and fragrance. There has been significant rise in number of prevalence of adults using e-cigarettes…
Electronic Voting Machine Market 2019-2025| Top key players: Gaurang Electronic …
This report titled as Electronic Voting Machine Market gives a brief about the comprehensive research and an outline of its growth in the market globally. Electronic voting is voting that uses electronic means to either aid or take care of casting and counting votes. Depending on the particular implementation, e-voting may use standalone electronic voting machines or computers connected to the Internet. It may encompass a range of Internet services,…
Electronic Voting Machine Market 2019-2025| Top key players: Gaurang Electronic …
The Electronic Voting Machine Market requires the prevailing regions in the market during the forecast period. Evidence on the region leading the market are some of the facets that are highlighted under this section of the report. A voting machine is a machine used to register and tabulate votes. The first voting machines were mechanical but it is increasingly more common to use electronic voting machines. Traditionally, a voting machine…
Electronic Wrapper Market Segmented By loading types semi-automatic electronic w …
A Revolutionary Product for the Packaging Industry
The electronic wrapper has been a revolutionizing product in the packaging industry. Electronic wrappers are easy to maintain and comfortable for size changes. The steel built electronic wrappers enable easy access for maintenance and cleaning, thus, gaining a considerable customer base from the packaging industries mainly for food and consumer products. An electronic wrapper is an automated machine, which is programmed to perform a…
Wearable Electronic Devices Market,Wearable Electronic Devices Industry, Global …
Latest industry research report on: Global Wearable Electronic Devices Market : Industry Size, Share, Research, Reviews, Analysis, Strategies, Demand, Growth, Segmentation, Parameters, Forecasts
This report studies the global Wearable Electronic Devices market status and forecast, categorizes the global Wearable Electronic Devices market size (value & volume) by manufacturers, type, application, and region. This report focuses on the top manufacturers in United States, Europe, China, Japan, South Korea and Taiwan and other…